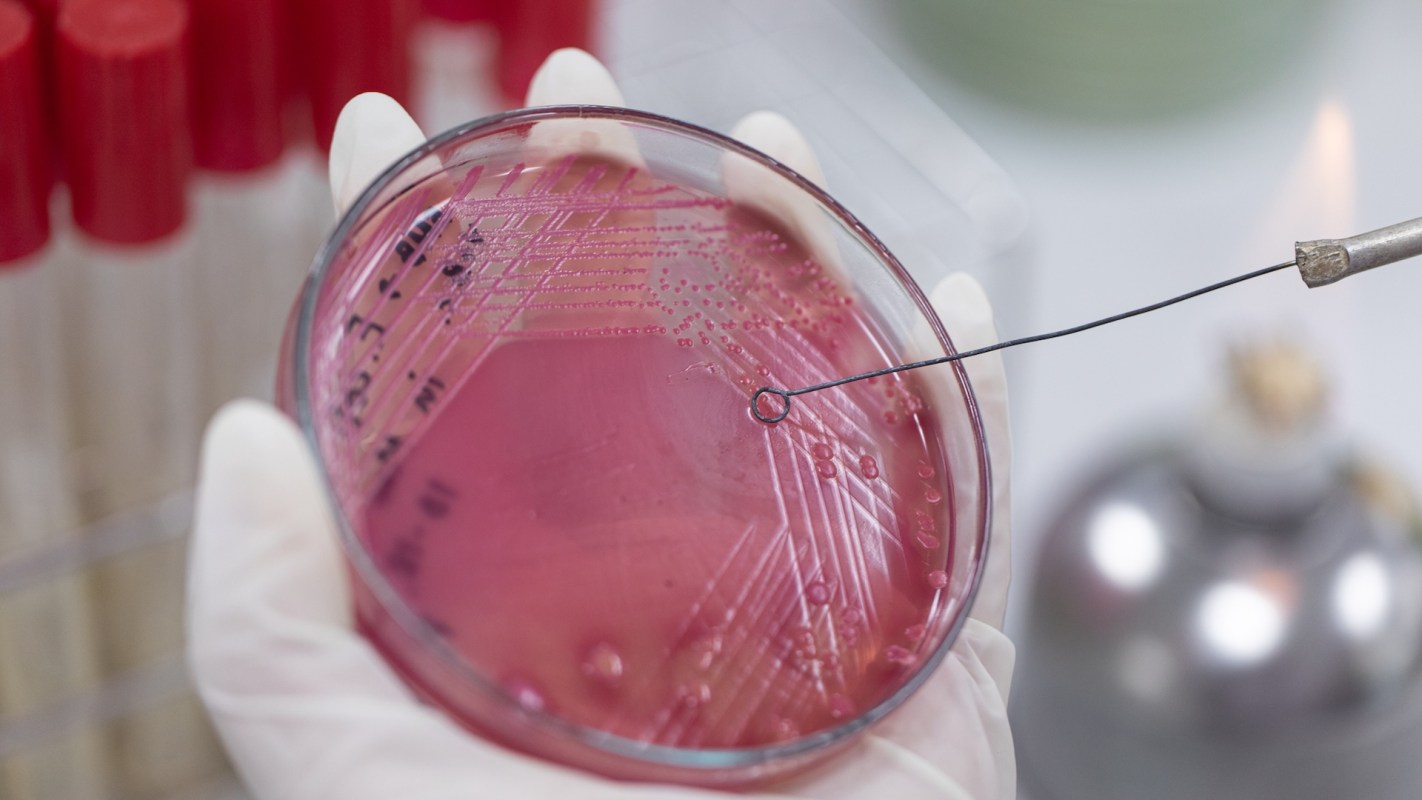
A new study reveals that microplastics may be acting as vehicles for dangerous, antibiotic-resistant bacteria.

A peer-reviewed study is raising alarms about the role our waste and wastewater systems play in spreading dangerous, antibiotic-resistant bacteria.
The data revealed that microplastics may be acting as vehicles for these microbes in ways scientists hadn't fully understood.
What's happening?
The study, published in Environment International, highlights troubling connections between the plastics in our waterways and rising public health risks.
Researchers from the University of Exeter examined how bacteria colonize microplastics in real environmental conditions, rather than in controlled lab environments.
They tested samples of polystyrene, bio-beads, and HDPE nurdles alongside natural materials across a pollution gradient influenced by wastewater runoff.
Their findings showed that downstream microplastic samples had higher concentrations of antimicrobial-resistant genes, including resistance to aminoglycosides, oxazolidinones, and tetracyclines.
They also detected worrying pathogen groups such as Flavobacteriia, Chlamydiia, and Sphingobacteriia, which increased in abundance the further they moved from cleaner upstream sites.
The study revealed that the plastics themselves — particularly polystyrene and HDPE — were more likely than natural materials to harbor and transport AMR bacteria.
"Our findings clearly show the importance of this multiple environment transect," the authors noted, per a school release.
"As this work highlights the diverse and sometimes harmful bacteria that grows on plastic in the environment, we recommend that any beach cleaning volunteer should wear gloves during clean-ups, and always wash your hands afterwards."
|
Do you think America has a plastic waste problem? Click your choice to see results and speak your mind. |
Why are antibiotic-resistant bacteria concerning?
The presence of antibiotic-resistant microbes on microplastics is both an environmental issue and a public health concern.
AMR infections directly killed more than a million people globally in 2019, according to the World Health Organization, and scientists warn the number could rise if resistant strains continue spreading through water systems, soil, and food webs.
Wastewater mishandling and aging infrastructure create ideal conditions for microplastics and bacteria to mix, travel, and accumulate in areas where people live, fish, swim, or source drinking water.
If these pathways remain unchecked, communities could face more exposure to pathogens that standard medical treatments aren't effective at treating — especially those living near waterways already impacted by pollution.
What can be done about microplastics?
Scientists say we need both systemic reforms and individual action to address this issue. Cities and states are beginning to push for upgraded wastewater infrastructure, stricter runoff safeguards, and microplastic monitoring. Some countries are even testing filters that capture microplastics before they enter rivers and lakes.
Readers can also help reduce pollution at the source by using less plastic, installing microfiber-catching laundry filters, and choosing reusable products wherever possible.
Scientists are also working on innovative solutions, such as optimizing wastewater handling and cleaning.
Experts say that slowing the spread of AMR requires controlling the pollutants that help resistant microbes survive and move through the environment.
Studies like this underscore how urgently we need those protections, as well as how improving waste systems today could safeguard entire communities in the future.
Get TCD's free newsletters for easy tips to save more, waste less, and make smarter choices — and earn up to $5,000 toward clean upgrades in TCD's exclusive Rewards Club.